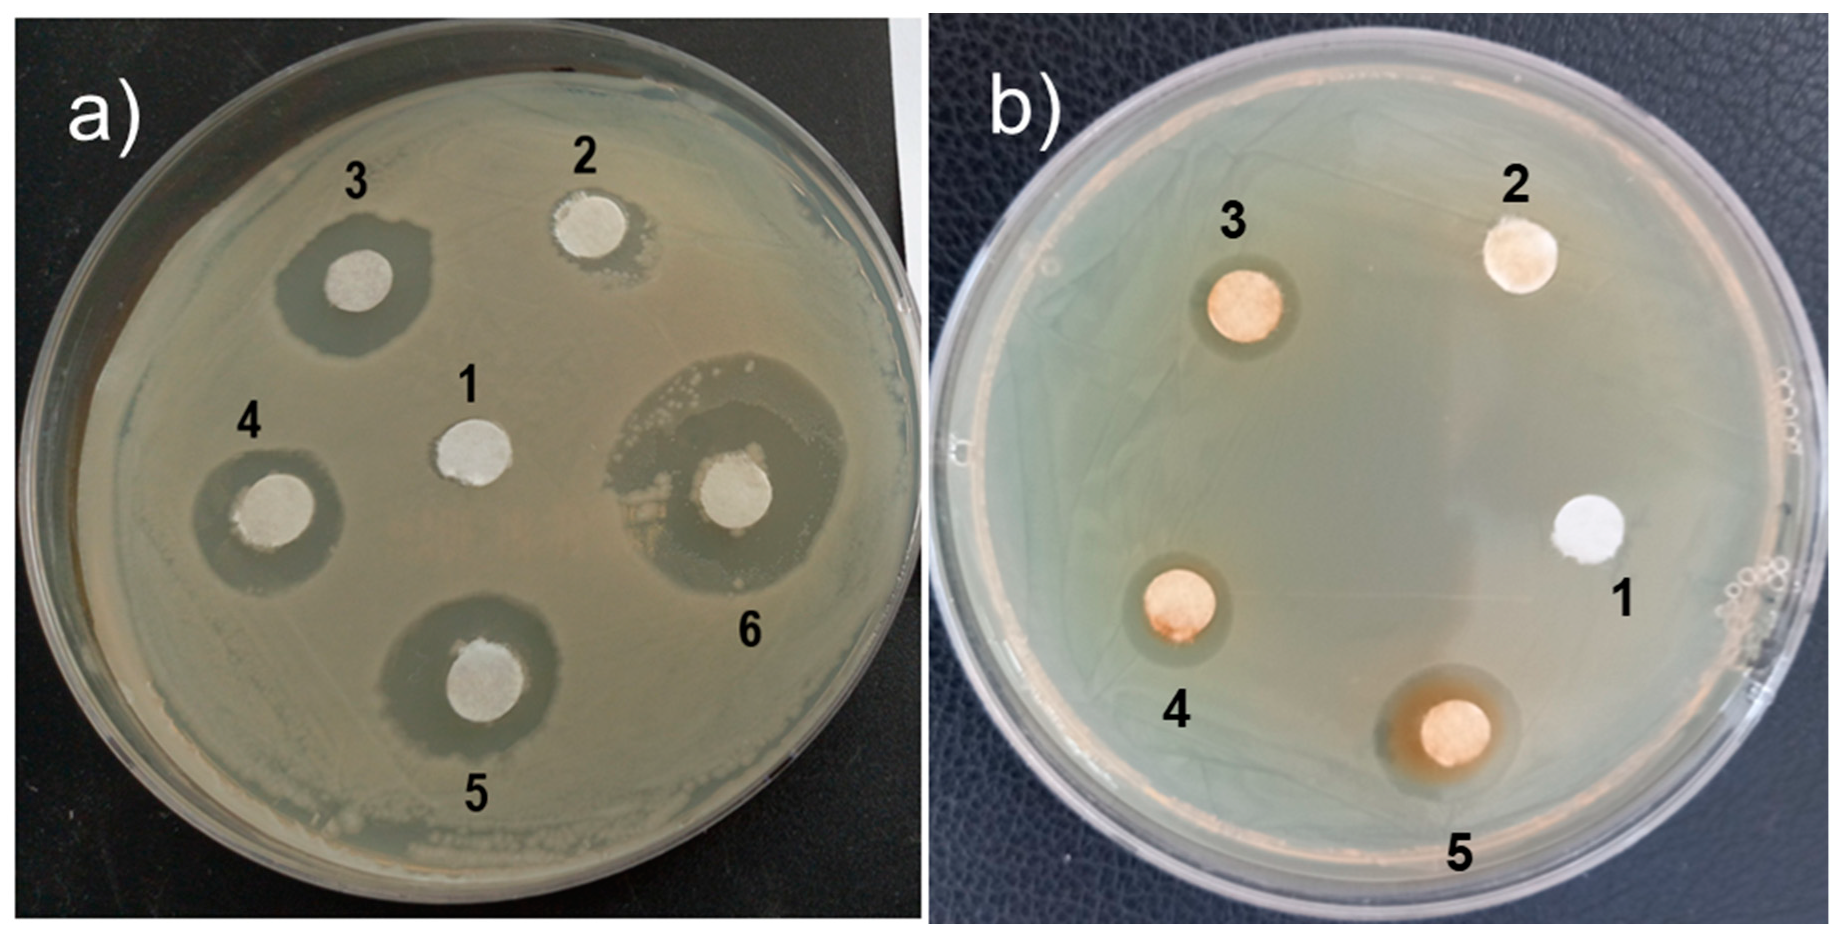

Gelatin-Coated TiO2/Pd Hybrid: A Potentially Useful Nanomaterial to Enhance Antibacterial and Anticancer Properties
Abstract
1. Introduction
2. Results and Discussion
2.1. Physical Characterization
2.2. Antibacterial Potential
2.3. In Vitro Cell Viability Assay
3. Materials and Methods
3.1. Materials
3.2. Material Characterization
3.3. Preparation of the Gelatin-Coated TiO2/Pd Nanomaterials
3.4. Antibacterial Potential
3.5. In Vitro Cell Viability Assay
4. Conclusions
Supplementary Materials
Author Contributions
Funding
Institutional Review Board Statement
Informed Consent Statement
Data Availability Statement
Acknowledgments
Conflicts of Interest
References
- Serwecinska, L. Antimicrobials and antibiotic-resistant bacteria: A risk to the environment and to public health. Water 2020, 12, 3313. [Google Scholar] [CrossRef]
- Cheng, Z.; Li, M.; Dey, R.; Chen, Y. Nanomaterials for cancer therapy: Current progress and perspectives. J. Hematol. Oncol. 2021, 14, 85. [Google Scholar] [CrossRef] [PubMed]
- Sharma, P.; Goyal, D.; Chudasama, B. Antibacterial activity of colloidal copper nanoparticles against gram-negative (Escherichia coli and Proteus vulgaris) bacteria. Lett. Appl. Microbol. 2022, 74, 695–706. [Google Scholar] [CrossRef] [PubMed]
- Anbu, P.; Gopinath, S.C.B.; Yun, H.S.; Lee, C.G. Temperature-dependent green biosynthesis and characterization of silver nanoparticles using balloon flower plants and their antibacterial potential. J. Mol. Struc. 2019, 1177, 302–309. [Google Scholar] [CrossRef]
- Faisal, S.; Jan, H.; Shah, S.A.; Shah, S.; Khan, A.; Akbar, M.T.; Rizwan, M.; Jan, F.; Wajidullah; Akhtar, N.; et al. Green synthesis of zinc oxide (ZnO) nanoparticles using aqueous fruit extracts of Myristica fragrans: Their characterizations and biological and environmental applications. ACS Omega 2021, 6, 9709–9722. [Google Scholar] [PubMed]
- Lalabadi, M.A.; Ehsani, A.; Divband, B.; Alizadeh-Sani, M. Antimicrobial activity of Titanium dioxide and Zinc oxide nanoparticles supported in 4A zeolite and evaluation the morphological characteristic. Sci. Rep. 2019, 9, 17439. [Google Scholar] [CrossRef] [PubMed]
- Divakaran, D.; Lakkakula, J.R.; Thakur, M.; Kumawat, M.K.; Srivastava, R. Dragon fruit extract capped gold nanoparticles: Synthesis and their differential cytotoxicity effect on breast cancer cells. Mater. Lett. 2019, 236, 498–502. [Google Scholar] [CrossRef]
- Anbu, P.; Gopinath, S.C.B.; Saravanakumar, K.; Vijayakumar, S.; Ramanathan, S.; Wang, M.H. Bimetallic mixed metal oxide (CuO/NiO) in fusion with nitrogen-doped graphene oxide: An alternate approach for developing potential biocarrier. J. Environ. Chem. Eng. 2021, 9, 105781. [Google Scholar] [CrossRef]
- Maheswari, P.; Harish, S.; Navaneethan, M.; Muthamizhchelvan, C.; Ponnusamy, S.; Hayakawa, Y. Bio-modified TiO2 nanoparticles with Withania sominifera, Eclipta prostrata and Glycyrrhiza glabra for anticancer and antibacterial applications. Mater. Sci. Eng. C 2020, 108, 110457. [Google Scholar] [CrossRef]
- Elsayed, K.A.; Alomari, M.; Drmosh, Q.A.; Manda, A.A.; Haladu, S.A.; Alade, I.O. Anticancer activity of TiO2/Au nanocomposite prepared by laser ablation technique on breast and cervical cancers, Optics. Laser Technol. 2022, 149, 107828. [Google Scholar] [CrossRef]
- Phan, T.T.V.; Huynh, T.C.; Manivasagan, P.; Mondal, S.; Oh, J. An up-to-date review on biomedical applications of palladium nanoparticles. Nanomaterials 2020, 10, 66. [Google Scholar] [CrossRef]
- MubarakAli, D.; Kim, H.; Venkatesh, P.S.; Kim, J.W.; Lee, S.Y. A systemic review on the synthesis, characterization, and applications of palladium nanoparticles in biomedicine. Appl. Biochem. Biotechnol. 2023, 195, 3699–3718. [Google Scholar] [CrossRef]
- Elsey, J.; Bubley, J.A.; Zhu, L.; Rao, S.; Sasaki, M.; Pollack, B.P.; Yang, L.; Arbiser, J.L. Palladium based nanoparticles for the treatment of advanced melanoma. Sci. Rep. 2019, 9, 3255. [Google Scholar] [CrossRef] [PubMed]
- Parthasarathy, A.; Vijayakumar, S.; Malaikozhundan, B.; Thangaraj, M.P.; Ekambaram, P.; Murugan, T.; Velusamy, P.; Anbu, P.; Vaseeharan, B. Chitosan-coated silver nanoparticles promoted antibacterial, antibiofilm, wound-healing of murine macrophages and antiproliferation of human breast cancer MCF 7 cells. Polym. Test. 2020, 90, 106675. [Google Scholar] [CrossRef]
- Peng, F.; Qiu, L.; Chai, R.; Meng, F.; Yan, C.; Chen, Y.; Qi, J.; Zhan, Y.; Xing, C. Conjugated polymer-based nanoparticles for cancer cell-targeted and image-guided photodynamic therapy. Macromol. Chem. Phy. 2018, 219, 1700440. [Google Scholar] [CrossRef]
- Caires, A.R.L.; Lima, T.H.N.; Abelha, T.F. Conjugated polymer nanoparticles with tunable antibacterial photodynamic capability. Mat. Adv. 2023, 4, 1664. [Google Scholar] [CrossRef]
- Arumugam, M.; Murugesan, B.; Sivakumar, P.M.; Pandiyan, N.; Chinnalagu, D.; Rangasamy, G.; Mahalingam, S. Electrospun silk fibroin and gelatin blended nanofibers functionalized with noble metal nanoparticles for enhanced biomedical applications. Proc. Biochem. 2023, 124, 221–234. [Google Scholar] [CrossRef]
- Ramirez-Barron, S.N.; Sanchez-Valdes, S.; Betancourt, R.; Gallardo, C.A.; Puente-Urbina, B.; Rodriguez-Fernandez, O.S.; Gunha, M.G.C.; Santos-Correia, M.T.O.; Sanchez-Martinez, Z.V. Preparation and characterizationof gelatin-gallic acid/ZnO nanocomposites with antibacteial properties as a promising multi-functional bioadhesive for wound dressing applications. Int. J. Adhesion Adjhesive. 2021, 104, 102749. [Google Scholar] [CrossRef]
- Abdelrady, H.; Hathout, R.M.; Osman, R.; Saleem, I.; Martada, N.D. Exploiting gelatin nanocarriers in the pulmonary delivery of methotrexate for lung cancer therapy. Eur. J. Pharm. Sci. 2019, 113, 115–126. [Google Scholar] [CrossRef]
- Kang, X.; Yang, Y.; Wang, L.; Wei, S.; Pan, D. Warm white light emitting diodes with gelatin-coated AglnS2/ZnS core/shell quantum. ACS. Appl. Mater. Interfaces 2015, 7, 27713–27719. [Google Scholar] [CrossRef]
- Suarasan, S.; Focsan, M.; Potara, M.; Soritau, O.; Florea, A.; Maniu, D.; Astilean, S. Doxorubicin-incorporated nanotherapeutic delivery system based on gelatin-coated gold nanoparticels: Formulation, drug release, and mutimodel imaging of cellular internalization. ACS. Appl. Mater. Interfaces 2016, 8, 22900–22913. [Google Scholar] [CrossRef] [PubMed]
- Zhang, Q.; Tan, K.; Zhang, Y.; Ye, Z.; Tan, W.S.; Lang, M. In situ controlled release of rhBMP-2 in gelatin-coated 3D porus poly (ε-caprolactone) scaffolds for homogeneous bone tissue formation. Biomacromolecules 2014, 15, 84–94. [Google Scholar] [CrossRef] [PubMed]
- He, Q.; Zhang, Y.; Cai, X.; Wang, S. Fabrication of gelatin–TiO2 nanocomposite film and its structural, antibacterial and physical properties. Int. J. Biol. Macromol. 2016, 84, 153–160. [Google Scholar] [CrossRef] [PubMed]
- Chekin, F.; Bagheri, S.; Abd Hamid, S.B. Synthesis and spectroscopic characterization of palladium-doped titanium dioxide catalyst. Bull. Mater. Sci. 2015, 38, 461–465. [Google Scholar] [CrossRef]
- Singh, B.; Arya, S.; Sharma, A.; Mahajan, P.; Gupta, J.; Singh, A.; Bharti, V. Effect of Pd concentration on the structural, morphological and photodiode properties of TiO2 nanoparticles. J. Mat. Sci. Mat. Electron. 2020, 31, 65–74. [Google Scholar] [CrossRef]
- Al-Taweel, S.S.; Saud, H.R. New route for synthesis of pure anatase TiO2 nanoparticles via utrasound-assisted sol-gel method. J. Chem. Pharm. Res. 2016, 8, 620–626. [Google Scholar]
- Gohari, G.; Mohammadi, A.; Akbari, A.; Panahirad, S.; Dadpour, M.R.; Fotopoulos, V.; Kimura, S. Titanium dioxide nanoparticles (TiO2 NPs) promote growth and ameliorate salinity stress effects on essential oil profile and biochemical attributes of Dracocephalum moldavica. Sci. Rep. 2020, 10, 912. [Google Scholar] [CrossRef] [PubMed]
- Deshmukh, K.K.; Hase, G.J.; Gaje, T.R.; Phatangare, N.D.; Shilpa, G.; Ashwini, V. Titanium oxide nanoparticles and degradation of dye by nanoparticles. Int. J. Mater. Sci. 2018, 13, 23–30. [Google Scholar]
- Chen, Y.; Ma, Y.; Lu, W.; Guo, Y.; Zhu, Y.; Lu, H.; Song, Y. Environmentally friendly gelatin/β-cyclodextrin composite fiber adsorbents for the efficient removal of dyes from wastewater. Molecules 2018, 23, 2473. [Google Scholar] [CrossRef]
- Jalaja, K.; Naskar, D.; Kundu, S.C.; James, N.R. Fabrication of cationized gelatin nanofibers by electrospinning for tissue regeneration. RSC Adv. 2015, 5, 89521–89530. [Google Scholar]
- Chen, Y.; Lu, W.; Guo, Y.; Zhu, Y.; Lu, H.; Wu, Y. Superhydrophobic coatings on gelatin-based films: Fabrication, characterization, and cytotoxicity studies. RSC Adv. 2018, 8, 23712–23719. [Google Scholar] [CrossRef]
- Sarmah, M.; Neog, A.B.; Boruah, P.K.; Das, M.R.; Bharali, P.; Bora, U. Effect of substrates on catalytic activity of biogenic palladium nanoparticles in C–C cross-coupling reactions. ACS Omega 2019, 4, 3329–3340. [Google Scholar] [CrossRef]
- Lezanska, M.; Olejniczak, A.; Rokicinska, A.; Kustrowski, P.; Lukaszewicz, J. Type A and B gelatin as precursors of silica-templated porous carbon with a specified number of nitrogen-and oxygen-containing functionalities. Mat. Exp. 2017, 7, 123–133. [Google Scholar] [CrossRef]
- Zhou, Y.; Kong, Y.; Kundu, S.; Cirillo, J.D.; Liang, H. Antibacterial activities of gold and silver nanoparticles against Escherichia coli and Bacillus calmette-Guerin. J. Nanobiotechnol. 2012, 10, 19. [Google Scholar] [CrossRef]
- Ranjan, S.; Ramalingam, C. Titanium dioxide nanoparticles induce bacterial membrane rupture by reactive oxygen species generation. Environ. Chem. Lett. 2016, 14, 487–494. [Google Scholar] [CrossRef]
- Srinivas, U.S.; Tan, B.W.Q.; Vellayappan, B.A.; Jeyasekharan, A.D. ROS and the DNA damage response in cancer. Redox Biol. 2019, 25, 101084. [Google Scholar] [CrossRef]
- Yan, L.P.; Gopinath, S.C.B.; Anbu, P.; Kasim, F.H.; Zulhaimi, H.I.; Yaakub, A.R.W. Characterization and anit-bacterial potenital of iron oxide nanoparticle processed eco-friendly by plant extract. Prep. Biochem. Biotechnol. 2020, 50, 1053–1062. [Google Scholar] [CrossRef]
- Anbu, P.; Gopinath, S.C.; Jayanthi, S. Synthesis of gold nanoparticles using Platycodon grandiflorum extract and its antipathogenic activity under optimal conditions. Nanomater. Nanotechnol. 2020, 10, 1–9. [Google Scholar] [CrossRef]
- Sathiyaseelan, A.; Saravanakumar, K.; Mariadoss, A.V.A.; Wang, M.H. Bimetallic silver-platinum (AgPt) nanoparticles and chitosan fabricated cotton gauze for enhanced antimicrobial and wound healing applications. Int. J. Biol. Macromol. 2022, 220, 1556–1569. [Google Scholar] [CrossRef] [PubMed]
- Sathiyaseelan, A.; Saravanakumar, K.; Manivasagan, P.; Jeong, M.S.; Jang, E.S.; Wang, M.H. Folic acid conjugated chitosan encapsulated palladium nanoclusters for NIR triggered photothermal breast cancer treatment. Carbohyd. Polym. 2022, 280, 119021. [Google Scholar] [CrossRef] [PubMed]
- Sathiyaseelan, A.; Saravanakumar, K.; Mariadoss, A.V.A.; Wang, M.H. Biocompatible fungal chitosan encapsulated phytogenic silver nanoparticles enhanced antidiabetic, antioxidant, and antibacterial activity. Int. J. Biol. Macromol. 2020, 153, 63–71. [Google Scholar] [CrossRef] [PubMed]

Disclaimer/Publisher’s Note: The statements, opinions and data contained in all publications are solely those of the individual author(s) and contributor(s) and not of MDPI and/or the editor(s). MDPI and/or the editor(s) disclaim responsibility for any injury to people or property resulting from any ideas, methods, instructions or products referred to in the content. |
© 2024 by the authors. Licensee MDPI, Basel, Switzerland. This article is an open access article distributed under the terms and conditions of the Creative Commons Attribution (CC BY) license (https://creativecommons.org/licenses/by/4.0/).
Share and Cite
Anbu, P.; Rethinasabapathy, M.; Sathiyaseelan, A.; Zhang, X.; Wang, M.-H.; Vijayakumar, S.; Huh, Y.S. Gelatin-Coated TiO2/Pd Hybrid: A Potentially Useful Nanomaterial to Enhance Antibacterial and Anticancer Properties. Int. J. Mol. Sci. 2024, 25, 5308. https://doi.org/10.3390/ijms25105308
Anbu P, Rethinasabapathy M, Sathiyaseelan A, Zhang X, Wang M-H, Vijayakumar S, Huh YS. Gelatin-Coated TiO2/Pd Hybrid: A Potentially Useful Nanomaterial to Enhance Antibacterial and Anticancer Properties. International Journal of Molecular Sciences. 2024; 25(10):5308. https://doi.org/10.3390/ijms25105308
Chicago/Turabian StyleAnbu, Periasamy, Muruganantham Rethinasabapathy, Anbazhagan Sathiyaseelan, Xin Zhang, Myeong-Hyeon Wang, Sekar Vijayakumar, and Yun Suk Huh. 2024. "Gelatin-Coated TiO2/Pd Hybrid: A Potentially Useful Nanomaterial to Enhance Antibacterial and Anticancer Properties" International Journal of Molecular Sciences 25, no. 10: 5308. https://doi.org/10.3390/ijms25105308
APA StyleAnbu, P., Rethinasabapathy, M., Sathiyaseelan, A., Zhang, X., Wang, M.-H., Vijayakumar, S., & Huh, Y. S. (2024). Gelatin-Coated TiO2/Pd Hybrid: A Potentially Useful Nanomaterial to Enhance Antibacterial and Anticancer Properties. International Journal of Molecular Sciences, 25(10), 5308. https://doi.org/10.3390/ijms25105308

